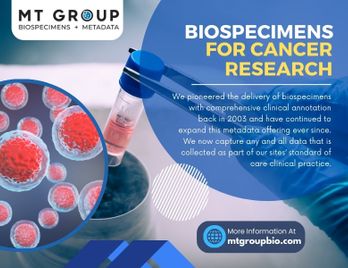

Add a CTA
Add Lead Capture Form
- 55 Characters
- 200 Characters
Mandatory
- 50 Characters


Choose Thumbnail
Original Media
Trim your video using the handles and Split button. Merge with other videos by clicking the Add Clip button.
Edit Captions
Engagement Insights
-
Video Views
0
-
Video Downloads
0
-
Call-to-Action Clicks
0
-
Average Completion Rate
0%
viewers
-

Someone from
Apr 14, 2021
-

Someone from
Apr 14, 2021
-

Someone from
Apr 14, 2021
Transcription
Change Language
Select target language

- Afrikaans
- Arabic
- Armenian
- Azerbaijani
- Belarusian
- Bosnian
- Bulgarian
- Catalan
- Chinese
- Croatian
- Czech
- Danish
- Dutch
- English - Current
- Estonian
- Finnish
- French
- Galician
- German
- Greek
- Hebrew
- Hindi
- Hungarian
- Icelandic
- Indonesian
- Italian
- Japanese
- Kannada
- Kazakh
- Korean
- Latvian
- Lithuanian
- Macedonian
- Malay
- Marathi
- Maori
- Nepali
- Norwegian
- Persian
- Polish
- Portuguese
- Romanian
- Russian
- Serbian
- Slovak
- Slovenian
- Spanish
- Swahili
- Swedish
- Tagalog
- Tamil
- Thai
- Turkish
- Ukrainian
- Urdu
- Vietnamese
- Welsh
Edit Transcription
Done
0/0
Enable transcriptions to enhance audience accessibility
Loading...
Correct
Engagement Insights
Preview Not Available

 Loading
Loading
File Not Found
The file you are looking for does not exist. It may have been removed.
To learn more, please visit our Help Center.
Preparing document for printing...
100%
Enter Password
Enter the password to open this PDF file.
 Delete
Delete

Video Options
Audio Options
Analytics
No activity yet
0 Comment